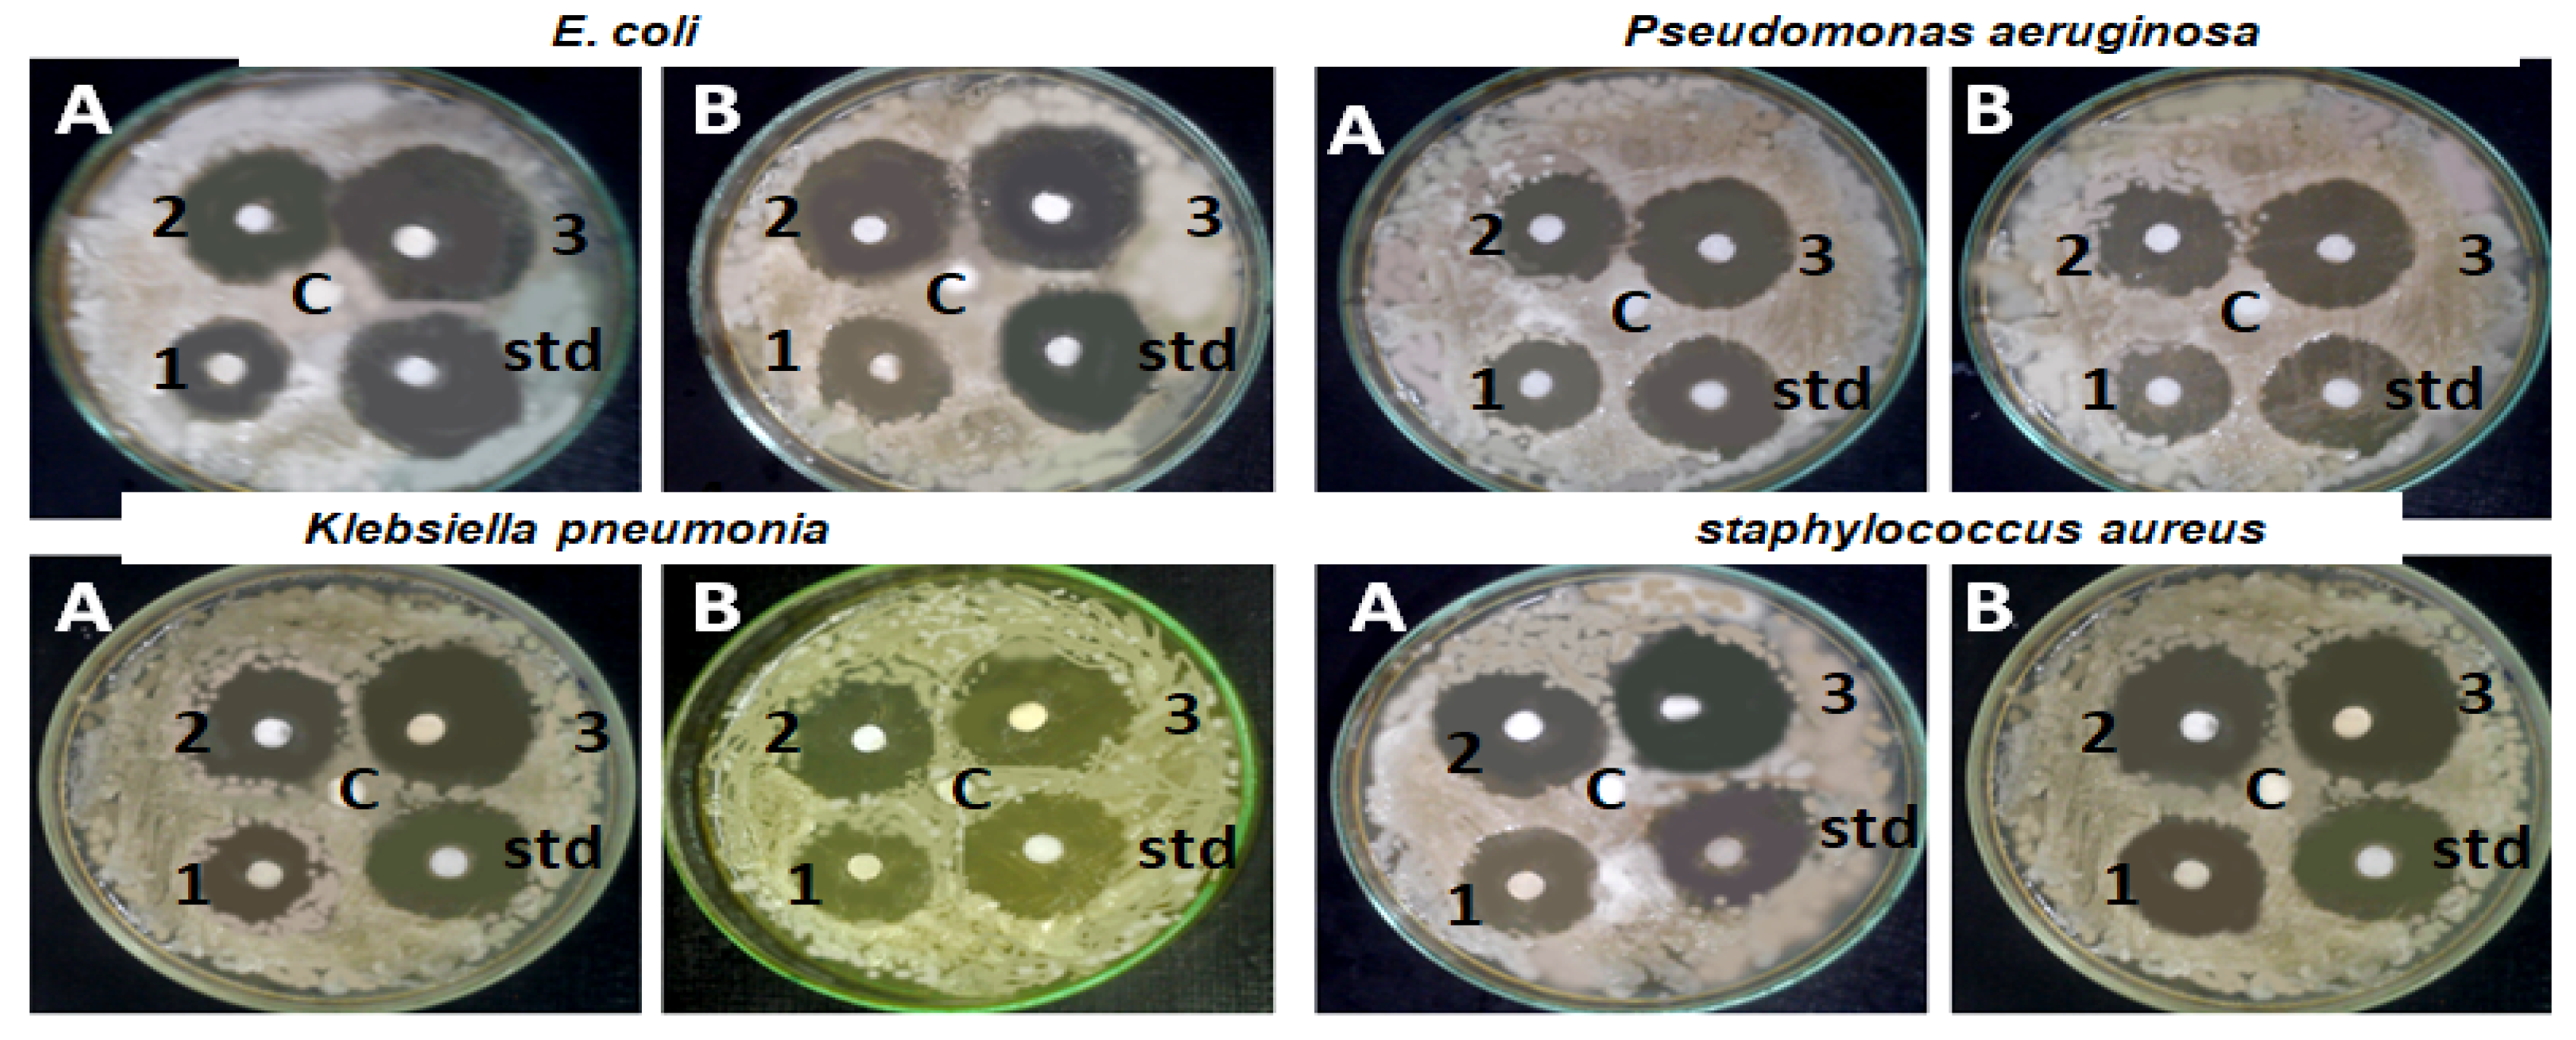
Molecules 28 07762 g008

Green Synthesis of Chitosan-Capped Gold Nanoparticles Using Salvia officinalis Extract: Biochemical Characterization and Antimicrobial and Cytotoxic Activities
Abstract
:1. Introduction
2. Results
2.1. Chemical Analysis of Aqueous Extract from S. officinalis Leaves
2.1.1. Chemical Composition
2.1.2. Phenolic Content
2.2. Preparation of Green-Synthesized AuNPs Conjugates
2.3. Characterization of BAuNPs
2.3.1. UV-Vis Spectroscopy
2.3.2. The Transmission Electron Microscopy Analysis of BAuNPs
2.3.3. EDX Analysis of BAuNPs
2.3.4. The FT-IR Spectrum Analysis of BAuNPs
2.3.5. Particle Size Analysis
2.4. DPPH and ABTS Scavenging Activities
2.5. Antibacterial Assay
2.6. In Vitro Anticancer Activity of BAuNPs and Chi/BAuNPs Composites
3. Discussion
4. Materials and Methods
4.1. Chemicals and Reagents
4.2. Plant Materials
4.3. Aqueous Extraction of S. officinalis
4.3.1. Chemical Characterization of S. officinalis Extract
4.3.2. Folin–Ciocalteu Assay of S. officinalis Extract
4.4. Green Synthesis of AuNPs with Aqueous Leaf Extract
4.5. Characterization of BAuNPs and Chi/BAuNPs
4.5.1. UV-Vis Absorption Spectrophotometer
4.5.2. FT-IR
4.5.3. TEM and Energy-Dispersive X-ray Spectroscopy
4.5.4. Particle Size Analysis
4.6. Synthesis of Chitosan–BAuNPs Conjugates
4.7. Antioxidant Activity of BAuNPs and Chi/BAuNPs
4.8. Antibacterial Assayof BAuNPs and Chi/BAuNPs
4.8.1. Microbial Strains
4.8.2. Antibacterial Assay
4.9. Anticancer Activity of BAuNPs and Chi/BAuNPs Conjugates
4.9.1. Cell Culture
4.9.2. Evaluation of Cytotoxicity by MTT Assay
4.10. Statistical Analysis
5. Conclusions
Author Contributions
Funding
Institutional Review Board Statement
Informed Consent Statement
Data Availability Statement
Conflicts of Interest
References
- Mostafa, E.M.; Abdelgawad, M.A.; Musa, A.; Alotaibi, N.H.; Elkomy, M.H.; Ghoneim, M.M.; Badawy, M.S.E.M.; Taha, M.N.; Hassan, H.M.; Hamed, A.A. Chitosan Silver and Gold Nanoparticle Formation Using Endophytic Fungi as Powerful Antimicrobial and Anti-Biofilm Potentialities. Antibiotics 2022, 11, 668. [Google Scholar] [CrossRef]
- Neu, H.C. The crisis in antibiotic resistance. Science 1992, 257, 1064–1073. [Google Scholar] [CrossRef] [PubMed]
- Du, W.; Chen, H.; Xiao, S.; Tang, W.; Shi, G. New insight on antimicrobial therapy adjustment strategies for gram-negative bacterial infection: A cohort study. Medicine 2017, 96, e6439. [Google Scholar] [CrossRef]
- Munita, J.M.; Arias, C.A. Mechanisms of Antibiotic Resistance. Microbiol. Spectr. 2016, 4, 481–511. [Google Scholar] [CrossRef] [PubMed]
- Jim, O. Tackling a Crisis for the Future Health and Wealth of Nations; Review on Antimicrobial Resistance: London, UK, 2014. [Google Scholar]
- Elshafie, H.S.; Caputo, L.; De Martino, L.; Sakr, S.H.; De Feo, V.; Camele, I. Study of Bio-Pharmaceutical and Antimicrobial Properties of Pomegranate (Punica granatum L.) Leathery Exocarp Extract. Plants 2021, 10, 153. [Google Scholar] [CrossRef] [PubMed]
- Elshafie, H.S.; Camele, I. An Overview of Metabolic Activity, Beneficial and Pathogenic Aspects of Burkholderia Spp. Metabolites 2021, 11, 321. [Google Scholar] [CrossRef] [PubMed]
- Puebla, L.E.J. Fungal infections in immunosuppressed patients. In Immunodeficiency; IntechOpen: London, UK, 2012. [Google Scholar]
- Chang, Y.L.; Yu, S.J.; Heitman, J.; Wellington, M.; Chen, Y.L. New facets of antifungal therapy. Virulence 2017, 8, 222–236. [Google Scholar] [CrossRef] [PubMed]
- Wadhwani, S.A.; Shedbalkar, U.U.; Singh, R.; Chopade, B.A. Biogenic selenium nanoparticles: Current status and future prospects. Appl. Microbiol. Bio. 2016, 100, 2555–2566. [Google Scholar] [CrossRef]
- Abadeer, N.S.; Murphy, C.J. Recent progress in cancer thermal therapy using gold nanoparticles. J. Phys. Chem. C 2016, 120, 4691–4716. [Google Scholar] [CrossRef]
- Abdelaziz, A.M.; Dacrory, S.; Hashem, A.H.; Attia, M.S.; Hasanin, M.; Fouda, H.M.; Kamel, S.; ElSaied, H. Protective role of zinc oxide nanoparticlesbased hydrogel against wilt disease of pepper plant. Biocatal. Agric. Biotechnol. 2021, 35, 102083. [Google Scholar] [CrossRef]
- Abdelmoneim, H.E.M.; Wassel, M.A.; Elfeky, A.S.; Bendary, S.H.; Awad, M.A.; Salem, S.S.; Mahmoud, S.A. Multiple Applications of CdS/TiO2 Nanocomposites Synthesized via Microwave-Assisted Sol–Gel. J. Clust. Sci. 2022, 33, 1119–1128. [Google Scholar] [CrossRef]
- Saied, E.; Eid, A.M.; Hassan, S.E.D.; Salem, S.S.; Radwan, A.A.; Halawa, M.; Saleh, F.M.; Saad, H.A.; Saied, E.M.; Fouda, A. The catalytic activity of greensynthesized magnesium oxide nanoparticles (Mgo-nps) for inhibiting the growth of pathogenic microbes, tanning effluent treatment, and chromium ion removal. Catalysts 2021, 11, 821. [Google Scholar] [CrossRef]
- Brasili, F.; Capocefalo, A.; Palmieri, D.; Capitani, F.; Chiessi, E.; Paradossi, G.; Bordi, F.; Domenici, F. Assembling patchy plasmonic nanoparticles with aggregation-dependent antibacterial activity. J. Colloid Interface Sci. 2020, 580, 419–428. [Google Scholar] [CrossRef] [PubMed]
- Elshafie, H.S.; Osman, A.; El-Saber, M.M.; Camele, I.; Abbas, E. Antifungal activity of green and chemically synthesized ZnO nanoparticles against Alternaria citri, the causal agent citrus black rot. Plant Pathol. J. 2023, 39, 265–274. [Google Scholar] [CrossRef]
- Ashraf, S.; Pelaz, B.; del Pino, P.; Carril, M.; Escudero, A.; Parak, W.J.; Soliman, M.G.; Zhang, Q.; Carrillo-Carrion, C. Gold-based nanomaterials for applications in nanomedicine. In Light-Responsive Nanostructured Systems for Applications in Nanomedicine; Springer: Berlin/Heidelberg, Germany, 2016; pp. 169–202. [Google Scholar]
- Bansal, S.A.; Kumar, V.; Karimi, J.; Singh, A.P.; Kumar, S. Role of gold nanoparticles in advanced biomedical applications. Nanoscale Adv. 2020, 2, 3764–3787. [Google Scholar] [CrossRef]
- Capocefalo, A.; Deckert-Gaudig, T.; Brasili, F.; Postorino, P.; Deckert, V. Unveiling the interaction of protein fibrils with gold nanoparticles by plasmon enhanced nano-spectroscopy. Nanoscale 2021, 13, 14469–14479. [Google Scholar] [CrossRef]
- Cho, K.; Wang, X.U.; Nie, S.; Shin, D.M. Therapeutic nanoparticles for drug delivery in cancer. Clin. Cancer Res. 2008, 14, 1310–1316. [Google Scholar] [CrossRef] [PubMed]
- Kumar, A.; Zhang, X.; Liang, X.J. Gold nanoparticles: Emerging paradigm for targeted drug delivery system. Biotechnol. Adv. 2013, 31, 593–606. [Google Scholar] [CrossRef]
- Salata, O.V. Applications of nanoparticles in biology and medicine. J. Nanobiotechnol. 2004, 2, 3. [Google Scholar] [CrossRef]
- Giljohann, D.A.; Seferos, D.S.; Daniel, W.L.; Massich, M.D.; Patel, P.C.; Mirkin, C.A. Gold nanoparticles for biology and medicine. Angew. Chem. Int. Ed. Engl. 2010, 49, 3280–3294. [Google Scholar] [CrossRef]
- Wang, A.Z.; Langer, R.; Farokhzad, O.C. Nanoparticle delivery of cancer drugs. Annu. Rev. Med. 2012, 63, 185–198. [Google Scholar] [CrossRef]
- Vankar, P.S.; Bajpai, D. Preparation of gold nanoparticles from Mirabilis jalapa flowers. Indian J. Biochem. Biophys. 2010, 47, 157–160. [Google Scholar] [PubMed]
- Salam, H.A.; Rajiv, P.; Kamaraj, M.; Jagadeeswaran, P.; Gunalan, S.; Sivaraj, R. Plants: Green route for nanoparticle synthesis. Int. Res. J. Biol. Sci. 2012, 1, 85–90. [Google Scholar]
- Shukla, D.; Vankar, P.S. Synthesis of plant parts mediated gold nanoparticles. Int. J. Green Nanotechnol. 2012, 4, 277–288. [Google Scholar] [CrossRef]
- Mittal, A.K.; Chisti, Y.; Banerjee, U.C. Synthesis of metallic nanoparticles using plant extracts. Biotechnol Adv. 2013, 31, 346–356. [Google Scholar] [CrossRef]
- Li, Y.; Gan, W.; Zhou, J.; Lu, Z.; Yang, C.; Ge, T. Hydrothermal synthesis of silver nanoparticles in Arabic gum aqueous solutions. Trans. Nonferrous Met. Soc. China 2015, 25, 2081–2086. [Google Scholar] [CrossRef]
- Praveenkumar, K.; Rabinal, M.K.; Kalasad, M.N.; Sankarappa, T.; Bedre, M.D. Chitosan capped silver nanoparticles used as pressure sensors. J. Appl. Phys. 2014, 5, 43–51. [Google Scholar]
- Mat Zain, N.; Stapley, A.G.F.; Shama, G. Green synthesis of silver and copper nanoparticles using ascorbic acid and chitosan for antimicrobial applications. Carbohydr. Polym. 2014, 112, 195–202. [Google Scholar] [CrossRef]
- Sibiya, P.N.; Moloto, M.J. Effect of concentration and pH on the size and shape of starch capped silver selenide nanoparticles. Chalcogenide Lett. 2014, 11, 577–588. [Google Scholar]
- Mat Yusuf, S.N.A.; Che Mood, C.N.A.; Ahmad, N.H.; Sandai, D.; Lee, C.K.; Lim, V. Optimization of biogenic synthesis of silver nanoparticles from flavonoid-rich Clinacanthus nutans leaf and stem aqueous extracts: Biogenic synthesis of C. nutans AgNPs. R. Soc. Open Sci. 2020, 7, 200065. [Google Scholar] [CrossRef]
- Mohammadi Nejad, R.; Shavandi, A.; Raie, D.S.; Sangeetha, J.; Soleimani, M.; Shokrian Hajibehzad, S.; Thangadurai, D.; Hospet, R.; Popoola, J.O.; Arzani, A.; et al. Plant molecular farming: Production of metallic nanoparticles and therapeutic proteins using green factories. Green Chem. 2019, 21, 1845–1865. [Google Scholar] [CrossRef]
- Elshafie, H.S.; Sakr, S.; Mang, S.M.; De Feo, V.; Camele, I. Antimicrobial activity and chemical composition of three essential oils extracted from Mediterranean aromatic plants. J. Med. Food. 2016, 19, 1096–1103. [Google Scholar] [CrossRef] [PubMed]
- Amrati, F.E.; Bourhia, M.; Slighoua, M.; Salamatullah, A.M.; Alzahrani, A.A.; Ullah, R.; Bari, A.; Bousta, D. Traditional medicinal knowledge of plants used for cancer treatment by communities of mountainous areas of Fez-Meknes-Morocco. Saudi Pharm. J. 2021, 29, 1185–1204. [Google Scholar] [CrossRef] [PubMed]
- Stagos, D.; Portesis, N.; Spanou, C.; Mossialos, D.; Aligiannis, N.; Chaita, E.; Panagoulis, C.; Reri, E.; Skaltsounis, L.; Tsatsakis, A.M.; et al. Correlation of Total Polyphenolic Content with Antioxidant and Antibacterial Activity of 24 Extracts From Greek Domestic Lamiaceae Species. Food Chem. Taxicol. 2012, 50, 4115–4124. [Google Scholar] [CrossRef] [PubMed]
- Orhan, I.E.; Senol, F.S.; Ercetin, T.; Kahraman, A.; Celep, F.; Akaydin, G.; Sener, B.; Dogan, M. Assessment of Anticholinesterase and Antioxidant Properties of Selected Sage (Salvia) Species with Their Total Phenol and Flavonoid Contents. Ind. Crop. Prod. 2013, 41, 21–30. [Google Scholar] [CrossRef]
- Ghorbani, A.; Esmaeilizadeh, M. Pharmacological Properties of Salvia Officinalis and its Components. J. Tradit. Complement. Med. 2017, 7, 433–440. [Google Scholar] [CrossRef]
- Ben Farhat, M.; Jordán, M.J.; Chaouech-Hamada, R.; Landoulsi, A.; Sotomayor, J.A. Variations in Essential oil, Phenolic Compounds and Antioxidant Activity of Tunisian Cultivated Salvia Officinalis L. J. Agric. Food Chem. 2009, 57, 10349–10356. [Google Scholar] [CrossRef] [PubMed]
- Takcı, D.K.; Ozdenefe, M.S.; Genc, S. Green synthesis of silver nanoparticles with an antibacterial activity using Salvia officinalis aqueous extract. J. Cryst. Growth 2023, 614, 127239. [Google Scholar] [CrossRef]
- Mihailović, V.; Srećković, N.; Nedić, Z.; Dimitrijević, S.; Matić, M.; Obradović, A.; Selaković, D.; Rosic, G.; Stanković, J.S.K. Green Synthesis of Silver Nanoparticles Using Salvia verticillata and Filipendula ulmaria Extracts: Optimization of Synthesis, Biological Activities, and Catalytic Properties. Molecules 2023, 28, 808. [Google Scholar] [CrossRef]
- Abomuti, M.A.; Danish, E.Y.; Firoz, A.; Hasan, N.; Malik, M.A. Green Synthesis of Zinc Oxide Nanoparticles Using Salvia officinalis Leaf Extract and Their Photocatalytic and Antifungal Activities. Biology 2021, 10, 1075. [Google Scholar] [CrossRef]
- Dincer, C.; Topuz, A.; Sahin-Nadeem, H.; Ozdemir, K.S.; Cam, I.B.; Tontul, I.; Gokturk, R.S.; Ay, S.T. A comparative study on phenolic composition, antioxidant activity and essential oil content of wild and cultivated sage (Salvia fruticosa Miller) as influenced by storage. Ind. Crops Prod. 2012, 39, 170–176. [Google Scholar] [CrossRef]
- Katanić, J.S.; Srećković, N.; Mišić, D.; Gašić, U.; Imbimbo, P.; Monti, D.M.; Mihailović, V. Bioactivity, biocompatibility and phytochemical assessment of lilac sage, Salvia verticillata L. (Lamiaceae)—A plant rich in rosmarinic acid. Ind. Crops Prod. 2020, 143, 111932. [Google Scholar] [CrossRef]
- Zengin, G.; Senkardes, I.; Mollica, A.; Picot-Allain, C.M.N.; Bulut, G.; Dogan, A.; Mahomoodally, M.F. New insights into the in vitro biological effects, in silico docking and chemical profile of clary sage—Salvia sclarea L. Comput. Biol. Chem. 2018, 75, 111–119. [Google Scholar] [CrossRef] [PubMed]
- Karadağ, A.E.; Demirci, B.; Çaşkurlu, A.; Demirci, F.; Okur, M.E.; Orak, D.; Sipahi, H.; Başer, K.H.C. In vitro antibacterial, antioxidant, anti-inflammatory and analgesic evaluation of Rosmarinus officinalis L. flower extract fractions. S. Afr. J. Bot. 2019, 125, 214–220. [Google Scholar] [CrossRef]
- Farhat, M.B.; Landoulsi, A.; Chaouch-Hamada, R.; Sotomayor, J.A.; Jordán, M.J. Characterization and quantification of phenolic compounds and antioxidant properties of Salvia species growing in different habitats. Ind. Crops Prod. 2013, 49, 904–914. [Google Scholar] [CrossRef]
- Arunachalam, K.; Annamalai, S.; Shanmugasundaram, H. One-step green synthesis and characterization of leaf extract-mediated biocompatible silver and gold nanoparticles from Memecylon umbellatum. Int. J. Nanomed. 2013, 8, 1307–1315. [Google Scholar] [CrossRef] [PubMed]
- Arockiya, A.R.F.; Arumugam, R.; Saravanan, S.; Anantharaman, P. Phyto fabrication of gold nanoparticles assisted by leaves of Suaeda monoica and its free radical scavenging property. J. Photochem. Photobiol. B 2014, 135, 75–80. [Google Scholar] [CrossRef] [PubMed]
- Zeiri, Y.; Elia, P.; Zach, R.; Hazan, S.; Kolusheva, S.; Porat, Z. Green synthesis of gold nanoparticles using plant extracts as reducing agents. Int. J. Nanomed. 2014, 9, 4007–4021. [Google Scholar] [CrossRef]
- Coates, J. Interpretation of Infrared Spectra, a practical approach. In Encyclopedia of Analytical Chemistry; Meyers, R.A., Ed.; John Wiley & Sons: Chichester, UK, 2000; pp. 10815–10837. [Google Scholar]
- Movasaghi, Z.; Rehman, D.; Rehman, I. Fourier Transform Infrared (FTIR) Spectroscopy of biological tissues. Appl. Spectrosc. Rev. 2008, 43, 134–179. [Google Scholar] [CrossRef]
- Kumar, S.; Lahlali, R.; Liu, X.; Karunakaran, C. Infrared spectroscopy combined with imaging: A new Developing analytical tool in health and plant science. Appl. Spectrosc. Rev. 2016, 51, 466–483. [Google Scholar] [CrossRef]
- Talari, A.C.S.; Garcia Martinez, M.A.; Movasaghi, Z.; Rehman, S.; Rehman, I. Advances in Fourier Transform Infrared (FTIR) spectroscopy of biological tissues. Appl. Spectrosc. Rev. 2016, 52, 456–506. [Google Scholar] [CrossRef]
- Wongsa, P.; Phatikulrungsun, P.; Prathumthong, S. FT-IR characteristics, phenolic profiles and inhibitory potential against digestive enzymes of 25 herbal infusions. Sci. Rep. 2022, 12, 6631. [Google Scholar] [CrossRef]
- Vijayan, R.; Joseph, S.; Mathew, B. Eco-friendly synthesis of silver and gold nanoparticles with enhanced antimicrobial, antioxidant, and catalytic activities. IET Nanobiotechnol. 2018, 12, 850–856. [Google Scholar] [CrossRef] [PubMed]
- Katas, H.; Moden, N.Z.; Lim, C.S.; Celesistinus, T.; Chan, J.Y.; Ganasan, P.; Suleman Ismail Abdalla, S. Biosynthesis and potential applications of silver and gold nanoparticles and their chitosan-based nanocomposites in nanomedicine. J. Nanotechnol. 2018, 2018, 4290705. [Google Scholar] [CrossRef]
- Panda, P.K.; Dash, P.; Chang, Y.-H.; Yang, J.-M. Improvement of chitosan water solubility by fumaric acid modification. Mater. Lett. 2022, 316, 132046. [Google Scholar] [CrossRef]
- Katas, H.; Alpar, H.O. Development and Characterisation of Chitosan Nanoparticles for SiRNA Delivery. J. Control. Release 2006, 115, 216–225. [Google Scholar] [CrossRef] [PubMed]
- Potara, M.; Jakab, E.; Damert, A.; Popescu, O.; Canpean, V.; Astilean, S. Synergistic antibacterial activity of chitosan-silver nanocomposites on Staphylococcus aureus. Nanotechnology 2011, 22, 135101. [Google Scholar] [CrossRef]
- Saha, S.K.; Roy, P.; Mondal, M.K.; Roy, D.; Gayen, P.; Chowdhury, P.; Babu, S.P.S. Development of chitosan based gold nanomaterial as an efficient antifilarial agent: A mechanistic approach. Carbohydr. Polym. 2017, 157, 1666–1676. [Google Scholar] [CrossRef]
- Shinde, S.; Folliero, V.; Chianese, A.; Zannella, C.; De Filippis, A.; Rosati, L.; Prisco, M.; Falanga, A.; Mali, A.; Galdiero, M.; et al. Synthesis of chitosan-coated silver nanoparticle bioconjugates and their antimicrobial activity against multidrug-resistant bacteria. Appl. Sci. 2021, 11, 9340. [Google Scholar] [CrossRef]
- Fuster, M.G.; Montalbán, M.G.; Carissimi, G.; Lima, B.; Feresin, G.E.; Cano, M.; Giner-Casares, J.J.; López-Cascales, J.J.; Enriz, R.D.; Víllora, G. Antibacterial Effect of Chitosan-Gold Nanoparticles and Computational Modeling of the Interaction between Chitosan and a Lipid Bilayer Model. Nanomaterials 2020, 10, 2340. [Google Scholar] [CrossRef]
- Husnu Can Baser, K. Biological and pharmacological activities of carvacrol and carvacrol bearing essential oils. Curr. Pharm. Des. 2008, 14, 3106–3120. [Google Scholar] [CrossRef]
- Sharifi-Rad, M.; Varoni, E.M.; Iriti, M.; Martorell, M.; Setzer, W.N.; del Mar Contreras, M.; Salehi, B.; Soltani-Nejad, A.; Rajabi, S.; Tajbakhsh, M.; et al. Carvacrol and human health: A comprehensive review. Phytother. Res. 2018, 32, 1675–1687. [Google Scholar] [CrossRef]
- Lee, J.Y.; Park, H.; Lim, W.; Song, G. α, β-Thujone Suppresses Human Placental Choriocarcinoma Cells via Metabolic Disruption. Reproduction 2020, 159, 745–756. [Google Scholar] [CrossRef] [PubMed]
- Pattnaik, S.; Subramanyam, V.R.; Bapaji, M.; Kole, C.R. Antibacterial and antifungal activity of aromatic constituents of essential oils. Microbios 1997, 89, 39–46. [Google Scholar] [PubMed]
- Tzakou, O.; Pitarokili, D.; Chinou, I.B.; Harvala, C. Composition and antibacterial activity of the essential oil of Salvia ringens. Planta Med. 2001, 67, 81–83. [Google Scholar] [CrossRef] [PubMed]
- Abu-Darwish, M.S.; Cabral, C.; Ferreira, I.; Gonçalves, M.; Cavaleiro, C.; Cruz, M.; Al-bdour, T.H.; Salgueiro, L. Essential oil of common sage (Salvia officinalis L.) from Jordan: Assessment of safety in mammalian cells and its antifungal and anti- inflammatory potential. BioMed. Res. Int. 2013, 2013, 538940. [Google Scholar] [CrossRef]
- Dob, T.; Berramdane, T.; Dahmane, D.; Benabdelkader, T.; Chelghoum, C. Chemical Composition ofthe essential oil of Salvia officinalis from Algeria. Chem. Nat. Compd. 2007, 43, 491–494. [Google Scholar] [CrossRef]
- Mokhtari, R.; Fard, M.K.; Rezaei, M.; Moftakharzadeh, S.A.; Mohseni, A. Antioxidant, Antimicrobial Activities, and Characterization of Phenolic Compounds of Thyme (Thymusvulgaris L.), Sage (Salviaofficinalis L.), and Thyme–Sage Mixture Extracts. J. Food Qual. 2023, 2602454, 9. [Google Scholar]
- Wojdylo, A.; Oszmianski, J.; Czemerys, R. Antioxidant activity and phenolic compound in 32 selected herbs. Food Chem. 2007, 105, 940–949. [Google Scholar] [CrossRef]
- Shan, B.; Cai, Y.Z.; Sun, M.; Corke, H. Antioxidant capacity of 26 spice extracts and characterization of theirphenolic constituents. J. Agric. Food Chem. 2005, 53, 7749–7759. [Google Scholar] [CrossRef]
- Tural, S.; Turhan, S. Antimicrobial and antioxidant properties of thyme (Thymus vulgaris L.), rosemary (Rosmarinus officinalis L.) and laurel (Lauris nobilis L.) essential oils andtheir mixtures. J. Food 2017, 42, 588–596. [Google Scholar] [CrossRef]
- Roby, M.H.H.; Sarhan, M.A.; Selim, K.A.H.; Khalel, K.I. Evaluation of antioxidant activity, total phenols and phenolic compounds in thyme (Thymus vulgaris L.), sage (Salviao&cinalis L.), and marjoram (Origanum majorana L.) extracts. Indus. Crops Prod. 2013, 43, 827–831. [Google Scholar]
- Sun, L.; Li, J.; Cai, J.; Zhong, L.; Ren, G.; Ma, Q. One pot synthesis of gold nanoparticles using chitosan with varying degree of deacetylation and molecular weight. Carbohydr. Polym. 2017, 178, 105–114. [Google Scholar] [CrossRef] [PubMed]
- Saravanakumar, K.; Mariadoss, A.V.A.; Sathiyaseelan, A.; Wang, M.-H. Synthesis and characterization of nano-chitosan capped gold nanoparticles with multifunctional bioactive properties. Int. J. Biol. Macromol. 2020, 165, 747–757. [Google Scholar] [CrossRef] [PubMed]
- Hashem, A.; Shehabeldine, A.M.; Ali, O.; Salem, S. Synthesis of Chitosan-Based Gold Nanoparticles: Antimicrobial and Wound-Healing Activities. Polymers 2022, 14, 2293. [Google Scholar] [CrossRef] [PubMed]
- Rodríguez-León, E.; Iñiguez-Palomares, R.; Navarro, R.E.; Herrera-Urbina, R.; Tánori, J.; Iñiguez-Palomares, C.; Maldonado, A. Synthesis of silver nanoparticles using reducing agents obtained from natural sources (Rumex hymenosepalus extracts). Nanoscale Res. Lett. 2013, 8, 318. [Google Scholar] [CrossRef] [PubMed]
- Croisier, F.; Jérôme, C. Chitosan-based biomaterials for tissue engineering. Eur. Polym. J. 2013, 49, 780–792. [Google Scholar] [CrossRef]
- Naskar, A.; Kim, K.-S. Recent advances in nanomaterial-based wound-healing therapeutics. Pharmaceutics 2020, 12, 499. [Google Scholar] [CrossRef]
- Mohandoss, S.; Pandimurugan, R.; Lee, Y.R.; Palanisamy, S.; Senthilkumar, M. In Situ synthesis and characterization of colloidal AuNPs capped nano-chitosan containing poly (2, 5-dimethoxyaniline) nanocomposites for biomedical applications. J. Biomater. Sci. Polym. Ed. 2022, 33, 1083–1101. [Google Scholar] [CrossRef]
- Genc, S.; Taghizadehghalehjoughi, A.; Yeni, Y.; Jafarizad, A.; Hacimuftuoglu, A.; Nikitovic, D.; Docea, A.O.; Mezhuev, Y.; Tsatsakis, A. Fe3O4 Nanoparticles in Combination with 5-FU Exert Antitumor Effects Superior to Those of the Active Drug in a Colon Cancer Cell Model. Pharmaceutics 2023, 15, 245. [Google Scholar] [CrossRef]
- Liu, J.Q.; Li, X.F.; Gu, C.Y.; da Silva, J.C.S.; Barros, A.L.; Alves, S.; Li, B.H.; Ren, F.; Batten, S.R.; Soares, T.A. A combined experimental and computational study of novel nanocage-based metal-organic frameworks for drug delivery. Dalton Trans. 2015, 44, 19370–19382. [Google Scholar] [CrossRef]
- Li, F.M.; Li, B.H.; Wang, C.F.; Zeng, Y.P.; Liu, J.Q.; Gu, C.Y.; Lu, P.F.; Mei, L. Encapsulation of pharmaceutical ingredient linker in metal-organic framework: Combined experimental and theoretical insight into the drug delivery. RSC Adv. 2016, 6, 47959–47965. [Google Scholar] [CrossRef]
- Qin, L.; Liang, F.L.; Li, Y.; Wu, J.A.; Guan, S.Y.; Wu, M.Y.; Xie, S.L.; Luo, M.S.; Ma, D.Y. A 2D Porous Zinc-Organic Framework Platform for Loading of 5-Fluorouracil. Inorganics 2022, 10, 202. [Google Scholar] [CrossRef]
- González-Tejero, M.R.; Casares-Porcel, M.; Sánchez-Rojas, C.P.; Ramiro-Gutierrez, J.M.; Molero-Mesa, J.; Pieroni, A.; Giusti, M.E.; Censorii, E.; Pasquale, C.D.; Della, A.; et al. Medicinal plants in the mediterranean area: Synthesis of the results of the project Rubia. J. Ethnopharmacol. 2008, 116, 341–357. [Google Scholar] [CrossRef] [PubMed]
- Gullberg, J.; Jonsson, P.; Nordst Röm, A.; Sjöström, M.; Moritz, T. Design of experiments: Anefficient strategy to identify f actors influencing extraction and derivatization of Arabidopsisthaliana samples in metabolomic studies with gas chromatography/mass spectrometry. Anal. Biochem. 2004, 331, 283–295. [Google Scholar] [CrossRef] [PubMed]
- Slinkard, K.; Singleton, V.L. Total phenol analysis: Automation and comparison with manual methods. Am. J. Enol. Vitic. 1977, 28, 49–55. [Google Scholar] [CrossRef]
- Dananjaya, S.; Udayangani, R.; Oh, C.; Nikapitiya, C.; Lee, J.; De Zoysa, M. Green synthesis, physio-chemical characterization and anti-candidal function of a biocompatible chitosan gold nanocomposite as a promising antifungal therapeutic agent. RSC Adv. 2017, 7, 9182–9193. [Google Scholar] [CrossRef]
- Zengin, G.; Sarikurkcu, C.; Aktumsek, A.; Ceylan, R. Sideritis galatica Bornm. A source of multifunctional agents for the management of oxidative damage, Alzheimer’s and diabetes mellitus. J. Func. Foods 2014, 11, 538–547. [Google Scholar] [CrossRef]
- Lu, Y.; Foo, L.Y. Polyphenolics of Salvia—A review. Phytochemistry 2002, 59, 117–140. [Google Scholar] [CrossRef]
- Suleiman, W.; El-Sheikh, H.; Abu-Elreesh, G.; Hashem, A. Recruitment of Cunninghamella echinulata as an Egyptian isolate to produce unsaturated fatty acids. Res. J. Pharm. Biol. Chem. Sci. 2018, 9, 764–774. [Google Scholar]
- Cui, Z.H.; He, H.L.; Wu, S.B.; Dong, C.L.; Lu, S.Y.; Shan, T.J.; Fang, L.X.; Liao, X.P.; Liu, Y.H.; Sun, J. Rapid screening of oils as substances which enhance antibiotic activity using a modified well diffusion method. Antibiotics 2021, 10, 463. [Google Scholar] [CrossRef] [PubMed]
- M02-A12; Performance Standards for Antimicrobial Disk Susceptibility Tests. Approved Standard—Twelfth Edition 2015. Clinical and Laboratory Standards Institute: Wayne, PA, USA, 2015.
- Panghal, M.; Kaushal, V.; Yadav, J.P. In Vitro antimicrobial activity of ten medicinal plants against clinical isolates of oral cancer cases. Ann. Clin. Microbiol. Antimicrob. 2011, 10, 21. [Google Scholar] [CrossRef]
- Sarker, S.A.; Nahar, L.; Kumarasamy, Y. Microtitre plate- based antimicrobial assay incorborating resazurin as an indicator of cell growth, and its application in the in vitro antibacterial screening of phytochemicals. Methods 2007, 42, 321–324. [Google Scholar] [CrossRef]
- Mosmann, T. Rapid colorimetric assay for cellular growth and survival: Application to proliferation and cytotoxicity assays. J. Immunol. Methods 1983, 65, 55–63. [Google Scholar] [CrossRef]
- Hamida, R.S.; Ali, M.A.; Almohawes, Z.N.; Alahdal, H.; Momenah, M.A.; Bin-Meferij, M.M. Green Synthesis of Hexagonal Silver Nanoparticles Using a Novel Microalgae Coelastrella aeroterrestrica Strain BA_Chlo4 and Resulting Anticancer, Antibacterial, and Antioxidant Activities. Pharmaceutics 2022, 14, 2002. [Google Scholar] [CrossRef] [PubMed]
- Chen, C.; Chen, H.; Zhang, Y.; Thomas, H.R.; Frank, M.H.; He, Y.; Xia, R. TBtools: An integrative toolkit developed for interactive analyses of big biological data. Mol. Plant 2020, 13, 1194–1202. [Google Scholar] [CrossRef] [PubMed]

| ID | Name of the Compound | Retention Time (min) | Peak Area (%) | Identification * |
|---|---|---|---|---|
| 1 | Rosmarinic acid | 4.089 | 11.4228361 | RI, MS |
| 2 | Sabinene | 4.628 | 1.07748449 | RI, MS |
| 3 | β-pinene | 5.443 | 0.55135934 | RI, MS |
| 4 | 5-O-Caffeoylquinic acids | 5.604 | 0.81992173 | RI, MS |
| 5 | Quercetin 3-O-rhamnoside | 5.960 | 1.29482077 | RI, MS |
| 6 | Caffeic acid hexoside | 17.287 | 10.1940505 | RI, MS |
| 7 | Ferulic acid | 17.432 | 1.87677256 | RI, MS |
| 8 | Dicaffeoylquinic acid | 18.532 | 7.76416171 | RI, MS |
| 9 | Ferulic acid derivative | 19.048 | 0.58989134 | RI, MS |
| 10 | Carnosic acid | 20.214 | 0.36857071 | RI, MS |
| 11 | Salvianolic acid C | 20.220 | 20.6931596 | RI, MS |
| 12 | Carvacrol | 36.884 | 6.03691661 | RI, MS |
| 13 | Camphor | 38.509 | 0.53245347 | RI, MS |
| 14 | Thujone | 38.816 | 2.37399975 | RI, MS |
| 15 | Methyl rosmarenate | 40.611 | 4.13873184 | RI, MS |
| 16 | Methyl carnosate | 40.89 | 1.68127316 | RI, MS |
| 17 | Apigenin | 49.700 | 8.6623548 | RI, MS |
| 18 | Luteolin-7-o-rutinose | 49.916 | 9.785653 | RI, MS |
| 19 | Apigenin-7-glucoside | 52.649 | 8.12475124 | RI, MS |
| 20 | Salvigenin | 55.912 | 2.0040468 | RI, MS |
| 21 | Total | -- | 99.993 | - |
| Concentrations (μg/mL) | % DPPH | % ABTS | |
|---|---|---|---|
| BAuNPs | 100 | 22.60 ± 1.06 | 17.65 ± 0.15 |
| 200 | 34.15 ± 4.62 | 28.21 ± 2.025 | |
| 300 | 51.08 ± 3.86 | 44.22 ± 4.02 | |
| Chi/BAuNPs | 100 | 29.32 ± 2.61 | 22.46 ± 1.62 |
| 200 | 54.28 ± 3.05 | 36.7 ± 1.09 | |
| 300 | 69.84 ± 6.15 | 53.15 ± 2.45 | |
| Ascorbic acid | 100 | 56.22 ± 4.6 | 36.62 ± 3.06 |
| 200 | 63.59 ± 6.8 | 51.82 ± 2.56 | |
| 300 | 81.05 ± 8.41 | 67.26 ± 3.87 | |
| Concentrations (µg/mL) | Inhibition Zone (mm) | ||||
|---|---|---|---|---|---|
| P. aeruginosa | E. coli | K. pneumonia | S. aureus | ||
| BAuNPs | 100 | 17 ± 0.012 | 11 ± 0.012 | 12 ± 0.014 | 14 ± 0.014 |
| 200 | 21 ± 0.15 | 14 ± 0.15 | 14 ± 0.12 | 16 ± 0.012 | |
| 300 | 28 ± 0.15 | 19 ± 0.16 | 20 ± 0.15 | 21 ± 0.13 | |
| Chi/ BAuNPs | 100 | 19 ± 0.13 | 18 ± 0.14 | 19 ± 0.021 | 21 ± 0.15 |
| 200 | 24 ± 0.12 | 23 ± 0.15 | 26 ± 0.12 | 27 ± 0.012 | |
| 300 | 30 ± 0.25 | 28 ± 0.11 | 29 ± 0.14 | 31 ± 0.024 | |
| Penicillin/streptomycin | 10 | 33 ± 0.13 | 30 ± 0.16 | 31 ± 0.18 | 32 ± 0.02 |
| Concentrations (µg/mL) | Microorganisms | ||||
|---|---|---|---|---|---|
| P. aeruginosa | E. coli | K. pneumonia | S. aureus | ||
| BAuNPs | MIC | 984 | 648 | 843 | 1352 |
| MBC | 546 | 386 | 406 | 617 | |
| Chi/ BAuNPs | MIC | 563 | 394 | 453 | 711 |
| MBC | 324 | 186 | 213 | 412 | |
| Penicillin/streptomycin | MIC | 36 | 12 | 16 | 43 |
| MBC | 16 | 8 | 10 | 19 | |
Disclaimer/Publisher’s Note: The statements, opinions and data contained in all publications are solely those of the individual author(s) and contributor(s) and not of MDPI and/or the editor(s). MDPI and/or the editor(s) disclaim responsibility for any injury to people or property resulting from any ideas, methods, instructions or products referred to in the content. |
© 2023 by the authors. Licensee MDPI, Basel, Switzerland. This article is an open access article distributed under the terms and conditions of the Creative Commons Attribution (CC BY) license (https://creativecommons.org/licenses/by/4.0/).
Share and Cite
Al-Sarraj, F.; Alotibi, I.; Al-Zahrani, M.; Albiheyri, R.; Alghamdi, M.A.; Nass, N.M.; Abd-Ellatif, S.; Makhlof, R.T.M.; Alsaad, M.A.; Sajer, B.H.; et al. Green Synthesis of Chitosan-Capped Gold Nanoparticles Using Salvia officinalis Extract: Biochemical Characterization and Antimicrobial and Cytotoxic Activities. Molecules 2023, 28, 7762. https://doi.org/10.3390/molecules28237762
Al-Sarraj F, Alotibi I, Al-Zahrani M, Albiheyri R, Alghamdi MA, Nass NM, Abd-Ellatif S, Makhlof RTM, Alsaad MA, Sajer BH, et al. Green Synthesis of Chitosan-Capped Gold Nanoparticles Using Salvia officinalis Extract: Biochemical Characterization and Antimicrobial and Cytotoxic Activities. Molecules. 2023; 28(23):7762. https://doi.org/10.3390/molecules28237762
Chicago/Turabian StyleAl-Sarraj, Faisal, Ibrahim Alotibi, Majid Al-Zahrani, Raed Albiheyri, Mashail A. Alghamdi, Nada M. Nass, Sawsan Abd-Ellatif, Raafat T. M. Makhlof, Mohammad A. Alsaad, Bayan H. Sajer, and et al. 2023. "Green Synthesis of Chitosan-Capped Gold Nanoparticles Using Salvia officinalis Extract: Biochemical Characterization and Antimicrobial and Cytotoxic Activities" Molecules 28, no. 23: 7762. https://doi.org/10.3390/molecules28237762
APA StyleAl-Sarraj, F., Alotibi, I., Al-Zahrani, M., Albiheyri, R., Alghamdi, M. A., Nass, N. M., Abd-Ellatif, S., Makhlof, R. T. M., Alsaad, M. A., Sajer, B. H., & Elshafie, H. S. (2023). Green Synthesis of Chitosan-Capped Gold Nanoparticles Using Salvia officinalis Extract: Biochemical Characterization and Antimicrobial and Cytotoxic Activities. Molecules, 28(23), 7762. https://doi.org/10.3390/molecules28237762

